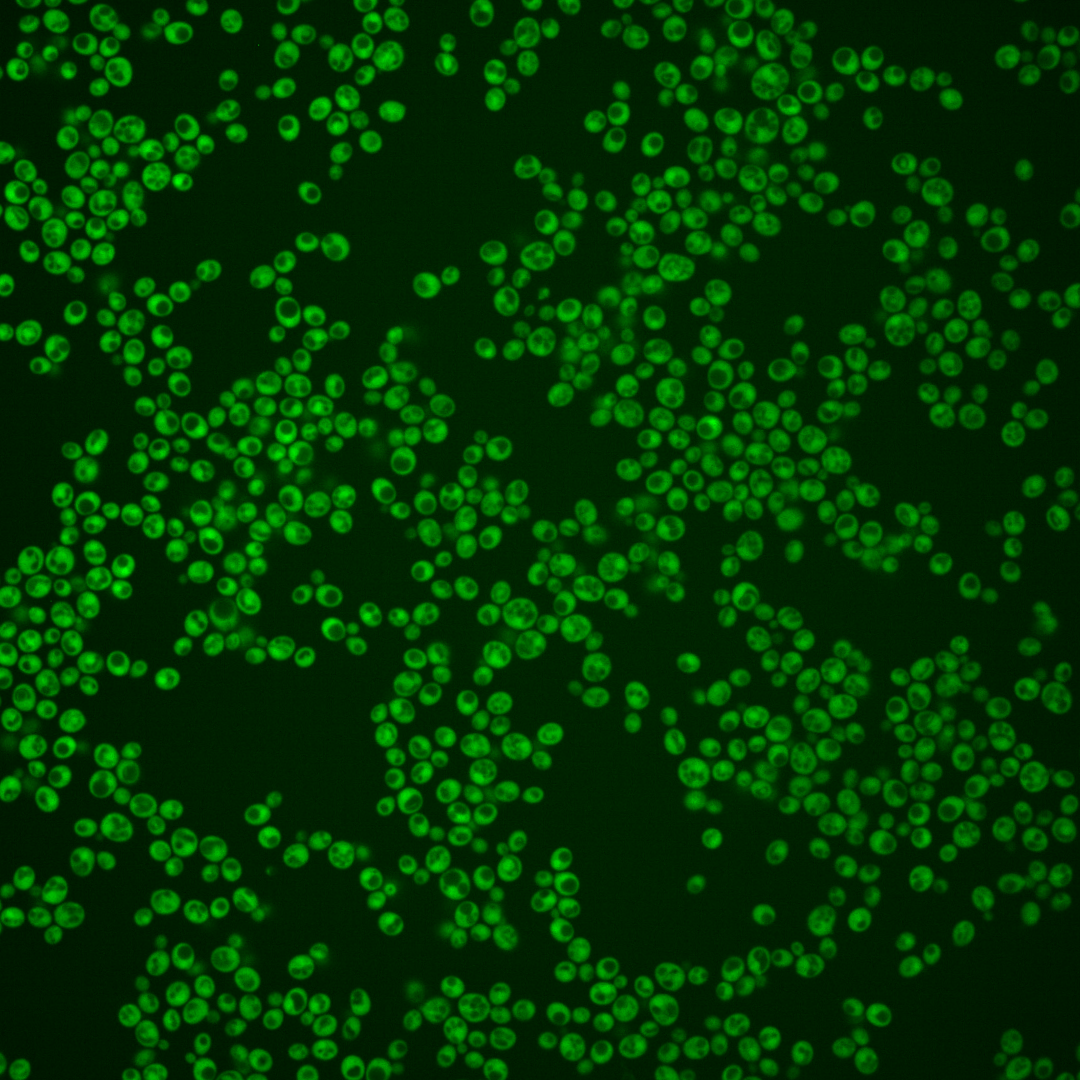
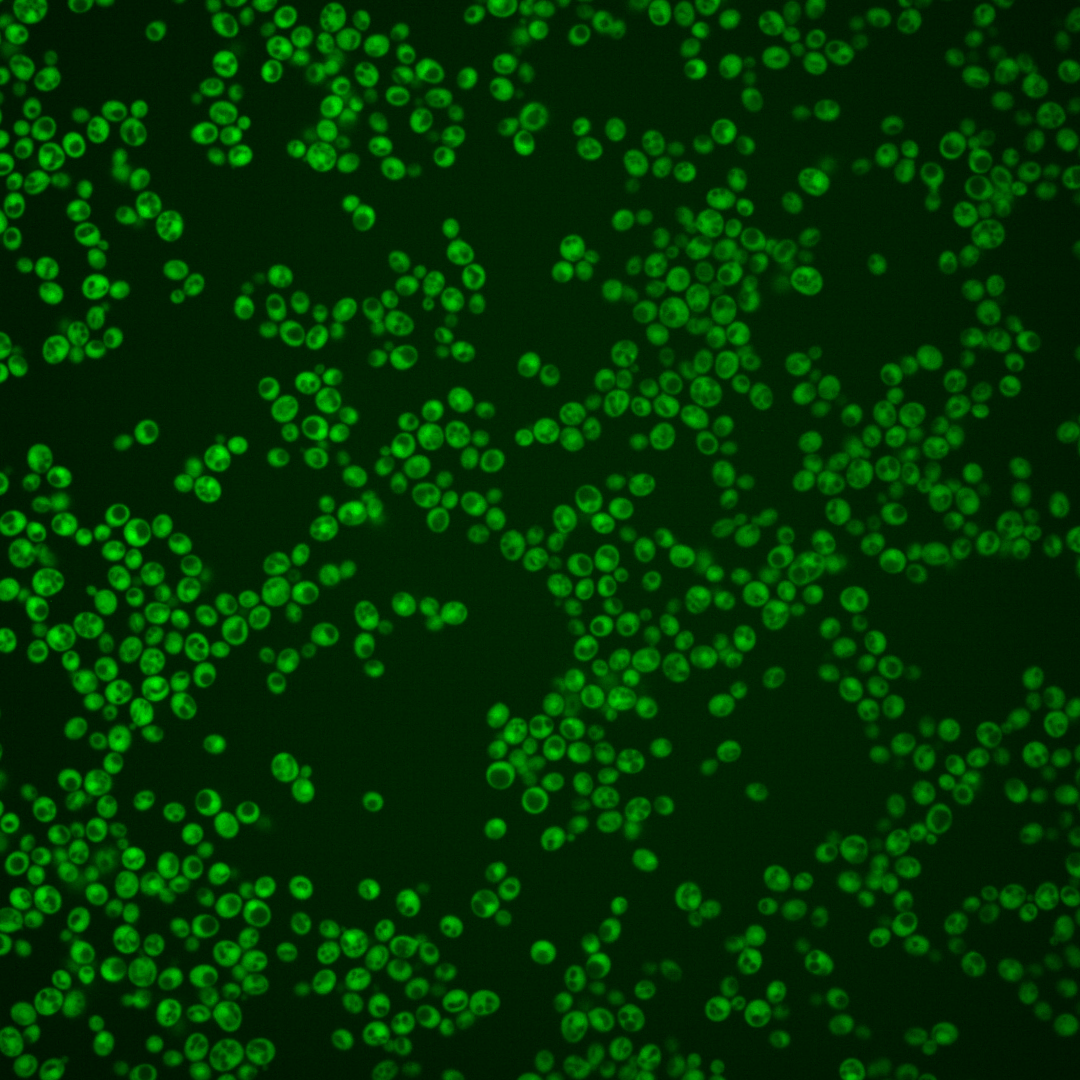
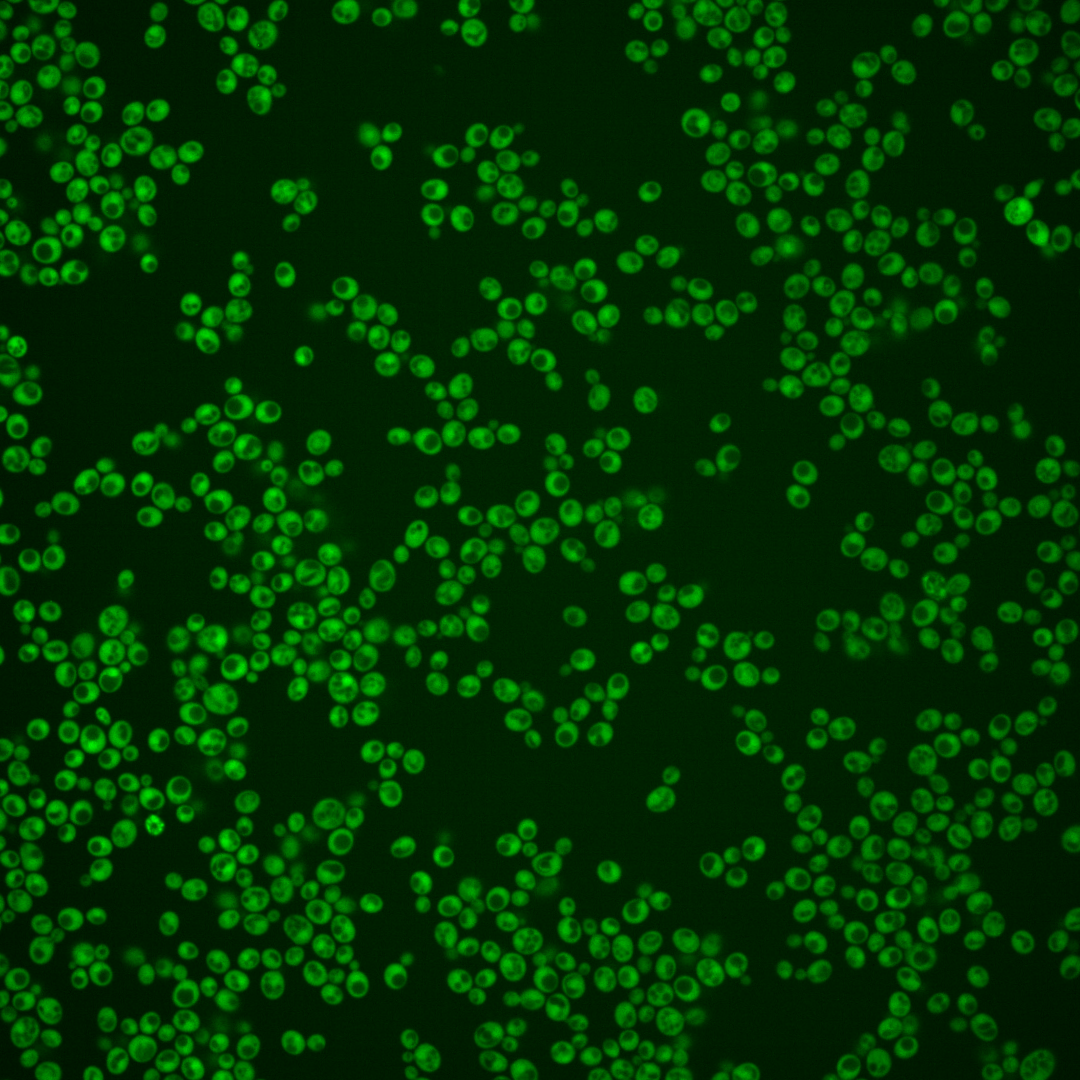
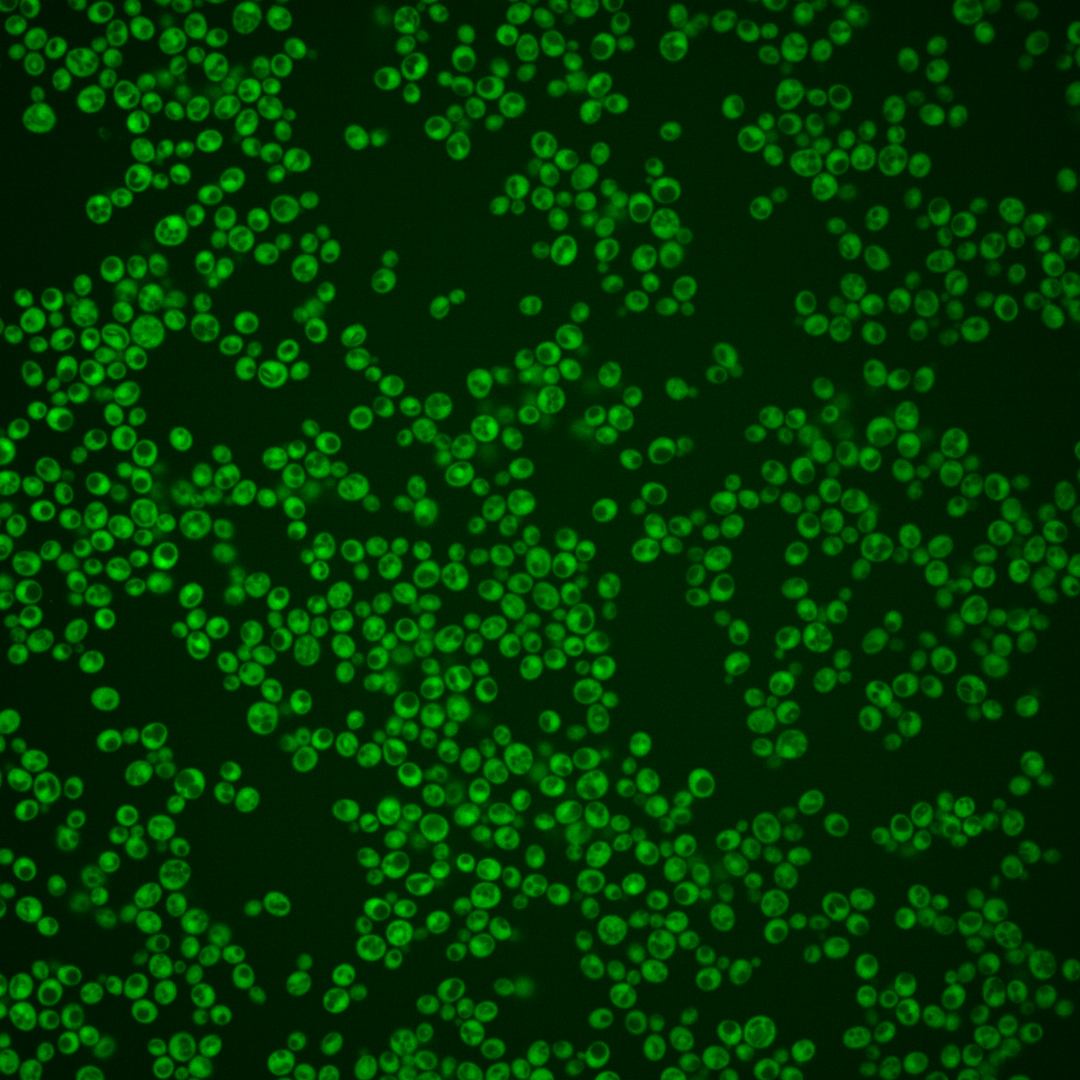

| Standard name | |
|---|---|
| Human Ortholog | |
| Description | FAD pyrophosphatase; hydrolyzes FAD as the preferred substrate but also acts on NADH and ADP-ribose at lower rates; activity is dependent upon K+ and divalent metal cations; green fluorescent protein (GFP)-fusion protein localizes to both the cytoplasm and nucleus; FPY1 is not an essential gene; protein abundance increases in response to DNA replication stress |
Micrographs




















































































Sub-cellular Localization
Yeast GFP Assignment
Protein Abundance
Localization Change
External localization resources
| ensLOC | DeepLoc | |||||||||||||||||||||||
|---|---|---|---|---|---|---|---|---|---|---|---|---|---|---|---|---|---|---|---|---|---|---|---|---|
| Localization | WT1 | WT2 | WT3 | RAP60 | RAP140 | RAP220 | RAP300 | RAP380 | RAP460 | RAP540 | RAP620 | RAP700 | HU80 | HU120 | HU160 | rpd3Δ_1 | rpd3Δ_2 | rpd3Δ_3 | WT1 | WT2 | WT3 | AF100 | AF140 | AF180 |
| Cortical Patches | 0 | 0 | 0 | 0 | 0 | 0 | 1 | 0 | 1 | 3 | 0 | 0 | 1 | 0 | 0 | 0 | 0 | 0 | 0 | 1 | 0 | 1 | 1 | 1 |
| Bud | 0 | 0 | 0 | 1 | 0 | 0 | 0 | 1 | 5 | 2 | 2 | 0 | 0 | 1 | 0 | 0 | 0 | 0 | 0 | 1 | 0 | 0 | 1 | 2 |
| Bud Neck | 0 | 0 | 0 | 0 | 0 | 0 | 0 | 0 | 0 | 0 | 0 | 0 | 0 | 0 | 0 | 0 | 0 | 0 | 0 | 0 | 0 | 0 | 0 | 0 |
| Bud Site | 0 | 0 | 0 | 0 | 0 | 0 | 0 | 0 | 0 | 0 | 0 | 0 | 0 | 0 | 0 | 0 | 0 | 0 | – | – | – | – | – | – |
| Cell Periphery | 1 | 1 | 2 | 2 | 2 | 4 | 2 | 4 | 4 | 6 | 9 | 1 | 1 | 1 | 2 | 11 | 10 | 6 | 0 | 0 | 0 | 0 | 0 | 0 |
| Cytoplasm | 228 | 450 | 110 | 138 | 221 | 141 | 143 | 184 | 140 | 145 | 146 | 107 | 246 | 211 | 307 | 646 | 569 | 472 | 247 | 430 | 121 | 203 | 238 | 258 |
| Endoplasmic Reticulum | 2 | 2 | 0 | 1 | 4 | 1 | 2 | 3 | 1 | 1 | 5 | 1 | 1 | 2 | 2 | 29 | 20 | 14 | 0 | 2 | 1 | 3 | 4 | 4 |
| Endosome | 0 | 0 | 0 | 0 | 0 | 0 | 0 | 1 | 1 | 0 | 0 | 0 | 0 | 1 | 3 | 1 | 1 | 2 | 2 | 2 | 0 | 2 | 5 | 4 |
| Golgi | 1 | 0 | 0 | 0 | 0 | 0 | 0 | 0 | 0 | 0 | 0 | 0 | 2 | 1 | 0 | 0 | 4 | 5 | 4 | 3 | 0 | 0 | 3 | 1 |
| Mitochondria | 2 | 1 | 0 | 2 | 3 | 1 | 5 | 13 | 46 | 10 | 30 | 13 | 0 | 0 | 0 | 5 | 6 | 3 | 0 | 4 | 0 | 0 | 3 | 0 |
| Nucleus | 2 | 3 | 1 | 1 | 8 | 5 | 4 | 6 | 6 | 4 | 8 | 4 | 1 | 4 | 1 | 6 | 17 | 13 | 1 | 4 | 1 | 4 | 2 | 2 |
| Nuclear Periphery | 0 | 3 | 0 | 0 | 0 | 0 | 0 | 0 | 1 | 0 | 0 | 0 | 0 | 0 | 0 | 0 | 2 | 0 | 0 | 1 | 0 | 1 | 0 | 0 |
| Nucleolus | 0 | 0 | 0 | 0 | 1 | 0 | 0 | 0 | 0 | 0 | 0 | 1 | 0 | 0 | 0 | 0 | 0 | 0 | 0 | 0 | 0 | 0 | 0 | 0 |
| Peroxisomes | 0 | 0 | 0 | 0 | 0 | 0 | 0 | 0 | 0 | 0 | 0 | 0 | 0 | 0 | 0 | 0 | 0 | 0 | 0 | 0 | 0 | 0 | 0 | 0 |
| SpindlePole | 0 | 0 | 0 | 0 | 0 | 0 | 0 | 0 | 0 | 0 | 0 | 0 | 0 | 0 | 0 | 0 | 0 | 0 | 0 | 0 | 0 | 0 | 0 | 0 |
| Vac/Vac Membrane | 9 | 5 | 0 | 4 | 14 | 4 | 28 | 63 | 43 | 58 | 33 | 11 | 9 | 9 | 8 | 33 | 67 | 37 | 8 | 7 | 0 | 4 | 1 | 2 |
| Unique Cell Count | 242 | 456 | 111 | 144 | 241 | 149 | 180 | 259 | 220 | 216 | 219 | 131 | 256 | 217 | 314 | 672 | 621 | 498 | 269 | 464 | 127 | 225 | 265 | 284 |
| Labelled Cell Count | 245 | 465 | 113 | 149 | 253 | 156 | 185 | 275 | 248 | 229 | 233 | 138 | 261 | 230 | 323 | 731 | 696 | 552 | 269 | 464 | 127 | 225 | 265 | 284 |
Yeast GFP Assignment
Protein Abundance
| Screen | WT1 | WT2 | WT3 | RAP60 | RAP140 | RAP220 | RAP300 | RAP380 | RAP460 | RAP540 | RAP620 | RAP700 | HU80 | HU120 | HU160 | rpd3Δ_1 | rpd3Δ_2 | rpd3Δ_3 | AF100 | AF140 | AF180 |
|---|---|---|---|---|---|---|---|---|---|---|---|---|---|---|---|---|---|---|---|---|---|
| Mean Cell GFP Intensity (1e-4) | 9.0 | 9.1 | 8.8 | 8.7 | 8.4 | 9.2 | 9.7 | 10.1 | 8.4 | 9.7 | 9.1 | 9.2 | 10.0 | 9.7 | 9.4 | 8.5 | 10.4 | 10.4 | 11.2 | 11.4 | 11.4 |
| Std Deviation (1e-4) | 1.7 | 1.4 | 1.4 | 1.6 | 1.8 | 1.6 | 1.6 | 1.8 | 2.0 | 2.0 | 1.9 | 2.0 | 2.0 | 1.3 | 1.5 | 1.2 | 1.5 | 1.6 | 2.0 | 2.3 | 2.0 |
| Intensity Change (Log2) | – | – | – | -0.01 | -0.07 | 0.07 | 0.14 | 0.2 | -0.07 | 0.14 | 0.04 | 0.07 | 0.18 | 0.13 | 0.09 | -0.05 | 0.24 | 0.24 | 0.34 | 0.37 | 0.37 |
Localization Change
| Localization | RAP60 | RAP140 | RAP220 | RAP300 | RAP380 | RAP460 | RAP540 | RAP620 | RAP700 | HU80 | HU120 | HU160 | rpd3Δ_1 | rpd3Δ_2 | rpd3Δ_3 |
|---|---|---|---|---|---|---|---|---|---|---|---|---|---|---|---|
| Cortical Patches | 0 | 0 | 0 | 0 | 0 | 0 | 0 | 0 | 0 | 0 | 0 | 0 | 0 | 0 | 0 |
| Bud | 0 | 0 | 0 | 0 | 0 | 0 | 0 | 0 | 0 | 0 | 0 | 0 | 0 | 0 | 0 |
| Bud Neck | 0 | 0 | 0 | 0 | 0 | 0 | 0 | 0 | 0 | 0 | 0 | 0 | 0 | 0 | 0 |
| Bud Site | 0 | 0 | 0 | 0 | 0 | 0 | 0 | 0 | 0 | 0 | 0 | 0 | 0 | 0 | 0 |
| Cell Periphery | 0 | 0 | 0 | 0 | 0 | 0 | 0 | 0 | 0 | 0 | 0 | 0 | 0 | 0 | 0 |
| Cytoplasm | -1.6 | -2.7 | -1.9 | -4.8 | -6.1 | -7.1 | -6.6 | -6.7 | -4.4 | -1.6 | -1.1 | -0.9 | -1.6 | -2.8 | -2.0 |
| Endoplasmic Reticulum | 0 | 0 | 0 | 0 | 0 | 0 | 0 | 0 | 0 | 0 | 0 | 0 | 0 | 0 | 0 |
| Endosome | 0 | 0 | 0 | 0 | 0 | 0 | 0 | 0 | 0 | 0 | 0 | 0 | 0 | 0 | 0 |
| Golgi | 0 | 0 | 0 | 0 | 0 | 0 | 0 | 0 | 0 | 0 | 0 | 0 | 0 | 0 | 0 |
| Mitochondria | 0 | 0 | 0 | 0 | 0 | 5.2 | 0 | 4.1 | 3.4 | 0 | 0 | 0 | 0 | 0 | 0 |
| Nucleus | 0 | 0 | 0 | 0 | 0 | 0 | 0 | 0 | 0 | 0 | 0 | 0 | 0 | 0 | 0 |
| Nuclear Periphery | 0 | 0 | 0 | 0 | 0 | 0 | 0 | 0 | 0 | 0 | 0 | 0 | 0 | 0 | 0 |
| Nucleolus | 0 | 0 | 0 | 0 | 0 | 0 | 0 | 0 | 0 | 0 | 0 | 0 | 0 | 0 | 0 |
| Peroxisomes | 0 | 0 | 0 | 0 | 0 | 0 | 0 | 0 | 0 | 0 | 0 | 0 | 0 | 0 | 0 |
| SpindlePole | 0 | 0 | 0 | 0 | 0 | 0 | 0 | 0 | 0 | 0 | 0 | 0 | 0 | 0 | 0 |
| Vacuole | 0 | 0 | 0 | 4.4 | 5.7 | 5.0 | 6.0 | 4.3 | 3.1 | 0 | 0 | 0 | 0 | 3.6 | 3.0 |
External localization resources
Images






























Protein Concentration and Protein Localization Data
| R1 | R2 | R3 | ||||||||||||||||
|---|---|---|---|---|---|---|---|---|---|---|---|---|---|---|---|---|---|---|
| G1 Pre-START | G1 Post-START | S/G2 | Metaphase | Anaphase | Telophase | G1 Pre-START | G1 Post-START | S/G2 | Metaphase | Anaphase | Telophase | G1 Pre-START | G1 Post-START | S/G2 | Metaphase | Anaphase | Telophase | |
| Concentration | 6.9948 | 8.3817 | 7.3385 | 5.6288 | 6.4836 | 7.797 | 15.5384 | 16.3932 | 15.866 | 15.1389 | 14.5145 | 16.1465 | 11.963 | 13.4492 | 12.643 | 11.1006 | 12.0824 | 12.7844 |
| Actin | 0.0566 | 0.0007 | 0.0407 | 0.0054 | 0.0443 | 0.0019 | 0.0039 | 0.0002 | 0.0014 | 0.0009 | 0.0001 | 0.001 | 0.0035 | 0.005 | 0.0057 | 0.0349 | 0.0005 | 0.0007 |
| Bud | 0.0018 | 0.0001 | 0.0004 | 0.0032 | 0.0063 | 0.0002 | 0.0002 | 0.0001 | 0.0001 | 0.0001 | 0.0001 | 0.0001 | 0.0002 | 0.0002 | 0.0001 | 0.0002 | 0 | 0.0001 |
| Bud Neck | 0.0052 | 0.0002 | 0.0013 | 0.0013 | 0.0007 | 0.0008 | 0.0004 | 0.0003 | 0.0005 | 0.0005 | 0.0005 | 0.001 | 0.0006 | 0.0009 | 0.0007 | 0.0005 | 0.0004 | 0.0009 |
| Bud Periphery | 0.0028 | 0 | 0.0004 | 0.0027 | 0.0093 | 0.0001 | 0.0001 | 0 | 0 | 0 | 0 | 0 | 0.0002 | 0 | 0 | 0.0002 | 0 | 0 |
| Bud Site | 0.0146 | 0.0002 | 0.0017 | 0.0422 | 0.0076 | 0.0001 | 0.0003 | 0.0003 | 0.0003 | 0.0001 | 0 | 0.0001 | 0.0005 | 0.0003 | 0.0002 | 0.0004 | 0 | 0.0001 |
| Cell Periphery | 0.0007 | 0 | 0.0001 | 0.0003 | 0.0003 | 0 | 0 | 0 | 0 | 0 | 0 | 0 | 0.0001 | 0.0001 | 0 | 0 | 0 | 0 |
| Cytoplasm | 0.6438 | 0.9799 | 0.8831 | 0.6892 | 0.7719 | 0.8985 | 0.9456 | 0.958 | 0.9591 | 0.9586 | 0.9577 | 0.937 | 0.9339 | 0.9741 | 0.9589 | 0.9164 | 0.9403 | 0.957 |
| Cytoplasmic Foci | 0.0346 | 0.0015 | 0.0065 | 0.0666 | 0.0197 | 0.0132 | 0.0021 | 0.0019 | 0.002 | 0.0038 | 0.001 | 0.0039 | 0.0046 | 0.0014 | 0.0039 | 0.0022 | 0.0015 | 0.0019 |
| Eisosomes | 0.0007 | 0 | 0.0002 | 0.0001 | 0.0001 | 0 | 0 | 0 | 0 | 0 | 0 | 0 | 0 | 0 | 0 | 0.0004 | 0 | 0 |
| Endoplasmic Reticulum | 0.0076 | 0.0013 | 0.0023 | 0.0009 | 0.0049 | 0.0029 | 0.0022 | 0.0014 | 0.0022 | 0.0031 | 0.0011 | 0.0024 | 0.0049 | 0.0011 | 0.0015 | 0.0015 | 0.0029 | 0.0029 |
| Endosome | 0.0352 | 0.0005 | 0.012 | 0.0627 | 0.0438 | 0.0123 | 0.0018 | 0.001 | 0.0016 | 0.0019 | 0.0005 | 0.0029 | 0.0058 | 0.0004 | 0.0013 | 0.0027 | 0.0086 | 0.0011 |
| Golgi | 0.0123 | 0.0001 | 0.0118 | 0.0354 | 0.0122 | 0.0044 | 0.0002 | 0.0001 | 0.0001 | 0.0001 | 0 | 0.0002 | 0.0007 | 0.0001 | 0.0004 | 0.0034 | 0.0004 | 0.0001 |
| Lipid Particles | 0.0154 | 0 | 0.008 | 0.0079 | 0.0074 | 0.0111 | 0.0001 | 0 | 0 | 0 | 0 | 0.0004 | 0.0006 | 0 | 0.0003 | 0.0014 | 0.0007 | 0.0001 |
| Mitochondria | 0.0262 | 0.0001 | 0.0099 | 0.0221 | 0.0041 | 0.0009 | 0.0004 | 0.0001 | 0.0002 | 0.0001 | 0.0001 | 0.0003 | 0.001 | 0.0001 | 0.0002 | 0.0179 | 0.0003 | 0.0002 |
| None | 0.0133 | 0.0016 | 0.0012 | 0.0009 | 0.0037 | 0.0012 | 0.0059 | 0.0034 | 0.0036 | 0.0013 | 0.0013 | 0.0034 | 0.0071 | 0.002 | 0.0026 | 0.002 | 0.0018 | 0.0035 |
| Nuclear Periphery | 0.0331 | 0.0019 | 0.0026 | 0.0009 | 0.0256 | 0.012 | 0.0035 | 0.0024 | 0.0041 | 0.0022 | 0.0021 | 0.0032 | 0.0056 | 0.001 | 0.002 | 0.0019 | 0.0187 | 0.002 |
| Nucleolus | 0.0018 | 0 | 0.0002 | 0.0011 | 0.0008 | 0.0001 | 0.0002 | 0 | 0 | 0 | 0 | 0 | 0.0002 | 0 | 0 | 0 | 0.0001 | 0 |
| Nucleus | 0.0685 | 0.0105 | 0.011 | 0.0031 | 0.0268 | 0.0325 | 0.0311 | 0.0287 | 0.0232 | 0.0263 | 0.034 | 0.0413 | 0.0262 | 0.0125 | 0.0198 | 0.0116 | 0.0209 | 0.0282 |
| Peroxisomes | 0.0057 | 0 | 0.0043 | 0.0466 | 0.0013 | 0.0023 | 0.0002 | 0.0001 | 0.0001 | 0.0001 | 0 | 0.0003 | 0.0007 | 0.0002 | 0.0007 | 0.0011 | 0.0001 | 0.0001 |
| Punctate Nuclear | 0.0132 | 0.0009 | 0.0005 | 0.0036 | 0.0054 | 0.0035 | 0.0014 | 0.001 | 0.0009 | 0.0005 | 0.0006 | 0.0017 | 0.0021 | 0.0003 | 0.0015 | 0.0004 | 0.0015 | 0.0008 |
| Vacuole | 0.0045 | 0.0005 | 0.0011 | 0.0029 | 0.0023 | 0.0013 | 0.0006 | 0.0007 | 0.0003 | 0.0003 | 0.0007 | 0.0005 | 0.0013 | 0.0003 | 0.0002 | 0.0006 | 0.0006 | 0.0004 |
| Vacuole Periphery | 0.0023 | 0.0001 | 0.0006 | 0.0009 | 0.0017 | 0.0007 | 0.0001 | 0.0001 | 0.0001 | 0.0001 | 0.0001 | 0.0001 | 0.0003 | 0 | 0.0001 | 0.0003 | 0.0006 | 0.0001 |
Sequencing Data
| R1 | R2 | |||||||||
|---|---|---|---|---|---|---|---|---|---|---|
| G1 Post-START | S/G2 | Metaphase | Anaphase | Telophase | G1 Post-START | S/G2 | Metaphase | Anaphase | Telophase | |
| Gene Expression | 44.1362 | 39.455 | 39.9237 | 47.8233 | 46.82 | 41.4383 | 42.6129 | 35.9001 | 43.6546 | 45.579 |
| Translational Efficiency | 1.2487 | 1.5983 | 1.4952 | 1.4788 | 1.3144 | 1.3476 | 1.5171 | 1.928 | 1.5043 | 1.5146 |
Hit Data
| Dataset | Hit |
|---|---|
| Protein Concentration | ✔ |
| Protein Localization | ✘ |
| Gene Expression | ✘ |
| Translational Efficiency | ✘ |
Endocytosis
| Temp | Actin Patch (Sac6-tdTomato) | Cortical Patch (Sla1-GFP) | Late Endosome (Snf7-GFP) | Vacuole (Vph1-GFP) |
|---|---|---|---|---|
| 37℃ | ||||
| RT |
Cell Cycle Omics
CYCLoPs (Fpy1-GFP)
| Gene / Allele | Actin Patch (Sac6-tdTomato) | Cortical Patch (Sla1-GFP) | Late Endosome (Snf7-GFP) | Vacuole (Sac6-tdTomato) |
|---|
| Gene | Images |
|---|
| Gene | Images |
|---|
Images are not yet available
Images are not yet available